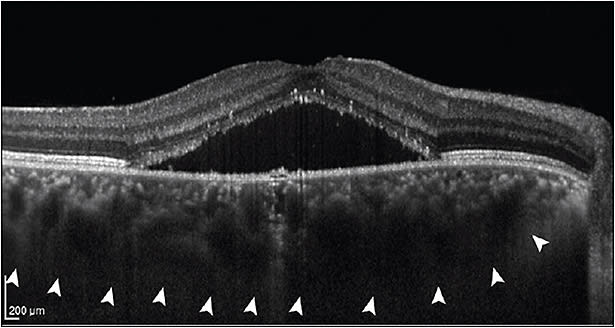
Figure 5. Central serous chorioretinopathy with serous detachment of the retina centrally demonstrating markedly thickened choroid (arrow heads). Image reprinted with permission from https://commons.wikimedia.org/wiki/File:Central_serous_chorioretinopathy_with_increased_choroidal_thickness.png.

Having undergone nearly continuous innovation over the past 2 decades, optical coherence tomography (OCT) now plays a key role in retina care and clinical trials, given its noninvasive ability to provide cross-sectional images of the retina. These high-resolution images facilitate detailed differentiation and measurement of retinal layers, guiding diagnosis and management of various conditions (Figure 1). Historically, the retina community has sought OCT findings or biomarkers that correlate with visual function and prognosis. Among these are central subfield thickness (CST), integrity of the ellipsoid zone (EZ, also known as the photoreceptor inner segment/outer segment, IS/OS, junction), disorganization of retinal inner layers (DRIL), and choroidal thickness, which are reviewed below.

CENTRAL SUBFIELD THICKNESS
Clinically, CST is an objective measurement of macular thickness readily available on OCT imaging. The central subfield is defined as the circular area 1 mm in diameter centered around the center point of the fovea, with its thickness provided as a quantifiable value on OCT software. In addition to its widespread use in retinal clinical care, CST has also been used in retinal clinical trials as an eligibility criterion, secondary endpoint and retreatment criterion. Consequently, there is great interest, and potentially some misunderstanding, in correlations between CST and visual acuity.
Macular Edema
Inherently, macular edema results in an increase in CST, and it occurs in common conditions such as diabetic macular edema (DME), retinal vein occlusion (RVO) (Figure 2), and noninfectious uveitis (NIU). However, only a modest correlation exists between best-corrected visual acuity (BCVA) and CST in these conditions.

In DME, for example, a recent post-hoc analysis found only a small to moderate negative correlation between baseline BCVA and CST, as well as between change in BCVA and change in CST, with no significant difference at 3 different time points.1 This modest correlation between visual acuity and CST was also previously noted in evaluation of focal laser treatment for DME.2 Likewise, another post-hoc analysis assessed this relationship following treatment with anti-VEGF therapy. Again, at baseline, a modest negative correlation was found between BCVA and central retinal thickness, as well as between the change in BCVA and the change in central retinal thickness at 12 months.3
This same study also assessed these correlations in RVO-related macular edema. Here, baseline BCVA did not correlate with baseline central retinal thickness; however, the analyzed RVO studies enrolled ischemic cases, a potentially confounding factor.3 The SCORE (standard care versus corticosteroid for retinal vein occlusion) study similarly showed low negative correlation between baseline BCVA and CST in CRVO related macular edema,4 with a low to moderate negative correlation between change in BCVA and change in CST at 2 different time points in both the intravitreal triamcinolone and observation groups.5 In the GENEVA study, which assessed the intravitreal dexamethasone implant in CRVO-related and BRVO-related macular edema, a similar low negative correlation was found between the change in CST and change in BCVA in those who received the implant.6
Additionally, macular edema in NIU has been analyzed. For example, the MUST (Multicenter Uveitis Steroid Treatment) trial showed a moderate negative correlation between BCVA and CST at baseline. This moderate correlation was also seen between the change in BCVA and change in CST at 6 months.7
In the authors’ recent study of CST in 1,063 clinical trial patients diagnosed with uveitic ME, RVO-associated ME, or DME, there were similar significant moderate negative linear correlations between BCVA and CST at baseline, with no significant differences between disease states. When pooling all 1,063 patient eyes regardless of disease state, there was a moderate negative linear correlation between baseline BCVA and CST (r=-0.55, P<.001). There was an average improvement of 3.3 ETDRS letters for every 100-mm reduction in CST. However, baseline CST accounted for only 30% of the total variation in baseline BCVA, on average, across disease states. With respect to change from baseline to 24 weeks, significant but low negative linear correlations also were found between BCVA and CST across these disease states; however, change in CST accounted for only 16% of the total variation in change in BCVA. Interestingly, acute and chronic ME showed similar baseline and 24-week change linear correlations. In addition, with lower baseline CST, there was a trend of decreased baseline and 24-week change correlations. Overall, this study is consistent with previous studies, suggesting that CST may provide context for clinical decision making, but only accounts for a minority of BCVA variation in uveitic ME, RVO-associated ME and DME.8
Neovascular AMD
As expected, in neovascular AMD, CST increases with development of intraretinal and subretinal fluid associated with choroidal neovascular membranes (Figure 3). In a study applying a deep-learning algorithm to OCT analysis in neovascular AMD patients, CST was found to have greatest association with visual acuity in first treated eyes, with greater CST correlating with worse visual acuity at baseline. In follow-up, however, this correlation becomes much less evident.9,10 Additionally, an aforementioned study concluded that the relationship between central retinal thickness and BCVA in neovascular AMD is small in magnitude, noting no correlation between changes in BCVA and changes in central retinal thickness compared to baseline.3

Overall, there appears to be a paucity of evidence elucidating a strong correlation between CST and BCVA. This inability to identify a causative relationship in macular edema may be a result of multiple factors, such as variation of normal CST, disruption of normal anatomic connections, ischemia, or functional tolerance of macular edema.11 Also, in AMD, there are likely additional contributing factors to vision loss, such as fibrosis and RPE atrophy. Although CST likely contributes to decreased visual function in these conditions, it has been found to only account for a minority of BCVA variation.
ELLIPSOID ZONE
The EZ is clinically defined as the photoreceptor IS/OS junction and is readily identified on OCT (Figure 1). Representing the anatomic relationship of photoreceptors, EZ integrity shows functional correlation in macular edema caused by the previously mentioned conditions. In addition, EZ integrity may represent an additional factor limiting the previously mentioned correlation between CST and BCVA.
Macular Edema
In the authors’ study of EZ in clinical trial patients diagnosed with uveitic ME and DME, the central subfield EZ was graded by a masked reading center and compared to BCVA. Ellipsoid zone was classified as normal, questionably abnormal, definitely abnormal (patchy), definitely abnormal (absent), or cannot grade. This analysis demonstrated progressively worsening mean baseline BCVA with each of the gradable central subfield EZ categories in 185 eyes with gradable EZ from 185 patients. However, central subfield EZ grade accounted for only 26% of the total variation in BCVA on average. Furthermore, although eyes with normal baseline central subfield EZ showed a significantly greater 24-week change in BCVA than those with abnormal findings, EZ grade could account for only 28% of the total variation in BCVA change. Consequently, this study suggests that central subfield EZ integrity, graded into 4 categories, may provide context for clinical decision making, like CST, but has limited utility as surrogate end point for BCVA or visual prognosis.8 These findings are generally consistent with a prior study evaluating DME eyes receiving anti-VEGF over 6 months.12
A limitation in this and other EZ analyses relates to the categorical grading and quantification in level of disruption. In contrast to the previously mentioned study, continuous measures of the central EZ-retinal pigment epithelium thickness, used as a surrogate for photoreceptor outer segment length, independently correlated with BCVA at multiple visits in patients treated with aflibercept for DME. This latter study also demonstrated significant improvement in EZ integrity correlating with resulting visual function over the course of treatment.13 Other studies have also evaluated the extent of EZ disruption as continuous variable.14 Additionally, it should be noted that EZ grading and analysis can be affected by shadowing from pathologic features such as intraretinal cysts, hemorrhage, and exudates.
Neovascular AMD
In neovascular AMD, EZ is commonly disrupted at the time of diagnosis. Treatment with anti-VEGF agents, however, has been associated with restoration of the EZ and favorable visual outcomes.15-17 Additionally, the extent of EZ damage may serve some predictive value for visual recovery.18 In a retrospective study, it was found that a majority of eyes (78.6%) with 200 μm to 800 μm of EZ disruption showed significant improvement in EZ compared to those with >800 μm of EZ disruption (19.0%). Thus, the improvement in EZ disruption may also serve as a predictive factor associated with long-term visual recovery, with the EZ status at 3 months closely associated with visual improvement.19
Geographic Atrophy
Progression to geographic atrophy can lead to severe central vision loss. With a complex multifactorial etiology, there currently is a relative lack of predictive early clinical features. A study comparing progressors and nonprogressors in AMD suggested that abnormalities of the ellipsoid zone were associated with higher risk of progression to geographic atrophy (and neovascular AMD).20 These findings imply that early anatomic changes identified at the level of the photoreceptors may be predictive of progression to advanced disease. Although EZ disruption may be a predictor of geographic atrophy development, this biomarker has limitations with respect to ultimate size or pattern of the atrophy.21
DISORGANIZATION OF RETINAL INNER LAYERS
Although increased CST and EZ disruption have some association with decreased BCVA, other factors contribute. Disorganization of retinal inner layers is a potentially important biomarker of reduced vision, because it possibly represents disruption of inner retinal layers such as the bipolar, amacrine, or horizontal cells. On OCT, DRIL is identified by lack of demarcation between the ganglion cell-inner plexiform layer complex, inner nuclear layer, and outer plexiform layer (Figure 4).

Macular Edema
Thus far, DRIL may have greater predictive value compared to previously mentioned biomarkers, especially in DME. One study evaluating DME demonstrated the significant association of foveal DRIL with reduced visual function, as well as the association between change in DRIL and visual outcomes, both of which were more consistent compared to other biomarkers, such as CST.22 These associations were further elucidated even in eyes with resolved DME.23,24 Further, while less evident at baseline in macular edema secondary to RVO, the change in DRIL following anti-VEGF therapy may be associated with visual acuity outcomes, potentially also serving as a useful biomarker in these cases.25-27 Similarly, in a randomized controlled trial in patients with uveitic macular edema, DRIL was found to be a useful surrogate biomarker for BCVA in both current and resolved edema.14
PACHYCHOROID
OCT can also be used to provide information regarding structure of the choroid, helping with characterization and distinction of pachychoroidal disorders. Normally supplying blood flow to the outer third of the retina, choroidal alterations can result in photoreceptor dysfunction and death. In this manner, OCT can quantify choroidal thickness as well as morphology of choroidal vessels, potentially serving as a biomarker in these disorders.
Increased choroidal thickness is defined as thickening greater than 390 mm, and it is a prominent feature in these conditions, along with pathologically dilated veins in the Haller layer, and thinning in Sattler and the choriocapillaris.28 These findings are characteristic in pachychoroidal disorders, such as pachychoroid pigment epitheliopathy and central serous chorioretinopathy (CSC), with resulting choroidal hyperpermeability, and ultimately serous detachment of the neurosensory retina in CSC (Figure 5).
Advanced pachychoroidal disorders can also result in neovascularization and may mimic neovascular AMD in these cases. Pachychoroidal neovasculopathy, for example, results in development of type 1 neovascular membrane underlying the RPE, with associated areas of choroidal thickening and dilated choroidal vessels. Similarly, polypoidal choroidal vasculopathy can result in a neovascular membrane in an area of abnormal choroidal capillary proliferation which develop aneurysms, or polyps, at their tips.29
Distinctions in these cases are important, as they represent different pathologic mechanisms compared to AMD. Studies have shown that these entities can be differentiated using OCT to identify thickened choroid and dilated outer choroidal vessels.30,31 Specifically, compared to CSC, AMD more frequently shows intraretinal fluid and pigment epithelial detachment, whereas CSC more frequently shows subretinal fluid and outer retinal changes.32,33
CONCLUSION
The noninvasive ability of OCT to provide high-quality images of retinal structure has proven to be invaluable to retina specialists. Current work has evaluated CST, EZ, DRIL, and choroidal thickness as prospective biomarkers. Continued investigation into OCT biomarkers may yield stronger associations with BCVA and visual prognosis. This research, potentially coupled with evolving artificial intelligence reading of retinal imaging, may yield meaningful prognostic and treatment guidance for retinal clinicians in the future. RP
REFRENCES
- Bressler SB, Odia I, Maguire MG, et al. Factors Associated With Visual Acuity and Central Subfield Thickness Changes When Treating Diabetic Macular Edema With Anti-Vascular Endothelial Growth Factor Therapy: An Exploratory Analysis of the Protocol T Randomized Clinical Trial. JAMA Ophthalmol. 2019;137(4):382-389. doi:10.1001/jamaophthalmol.2018.6786
- Diabetic Retinopathy Clinical Research Network, Browning DJ, Glassman AR, et al. Relationship between optical coherence tomography-measured central retinal thickness and visual acuity in diabetic macular edema. Ophthalmology. 2007;114(3):525-536. doi:10.1016/j.ophtha.2006.06.052
- Ou WC, Brown DM, Payne JF, Wykoff CC. Relationship Between Visual Acuity and Retinal Thickness During Anti-Vascular Endothelial Growth Factor Therapy for Retinal Diseases. Am J Ophthalmol. 2017;180:8-17. doi:10.1016/j.ajo.2017.05.014
- Scott IU, VanVeldhuisen PC, Oden NL, et al. SCORE Study report 1: baseline associations between central retinal thickness and visual acuity in patients with retinal vein occlusion. Ophthalmology. 2009;116(3):504-512. doi:10.1016/j.ophtha.2008.10.017
- Ip MS, Scott IU, VanVeldhuisen PC, et al. A randomized trial comparing the efficacy and safety of intravitreal triamcinolone with observation to treat vision loss associated with macular edema secondary to central retinal vein occlusion: the Standard Care vs Corticosteroid for Retinal Vein Occlusion (SCORE) study report 5 [published correction appears in Arch Ophthalmol. 2009 Dec;127(12):1648]. Arch Ophthalmol. 2009;127(9):1101-1114. doi:10.1001/archophthalmol.2009.234
- Danis RP, Sadda S, Jiao J, Li XY, Whitcup SM. Relationship between retinal thickness and visual acuity in eyes with retinal vein occlusion treated with dexamethasone implant. Retina. 2016;36(6):1170-1176. doi:10.1097/IAE.0000000000000851
- Sugar EA, Jabs DA, Altaweel MM, et al. Identifying a clinically meaningful threshold for change in uveitic macular edema evaluated by optical coherence tomography. Am J Ophthalmol. 2011;152(6):1044-1052.e5. doi:10.1016/j.ajo.2011.05.028
- Ciulla TA, Kapik B, Grewal DS, Ip MS. Visual acuity in retinal vein occlusion, diabetic, and uveitic macular edema: central subfield thickness and ellipsoid zone analysis [published online ahead of print, 2020 Oct 29]. Ophthalmol Retina. 2020;S2468-6530(20)30429-2. doi:10.1016/j.oret.2020.10.016
- Moraes G, Fu DJ, Wilson M, et al. Quantitative analysis of OCT for neovascular age-related macular degeneration using deep learning [published online ahead of print, 2020 Sep 24]. Ophthalmology. 2020;S0161-6420(20)30930-1. doi:10.1016/j.ophtha.2020.09.025
- Keane PA, Liakopoulos S, Chang KT, et al. Relationship between optical coherence tomography retinal parameters and visual acuity in neovascular age-related macular degeneration. Ophthalmology. 2008;115(12):2206-2214. doi:10.1016/j.ophtha.2008.08.016
- Deák GG, Schmidt-Erfurth UM, Jampol LM. Correlation of central retinal thickness and visual acuity in diabetic macular edema. JAMA Ophthalmol. 2018;136(11):1215-1216. doi:10.1001/jamaophthalmol.2018.3848
- Campos A, Campos EJ, do Carmo A, et al. Evaluation of markers of outcome in real-world treatment of diabetic macular edema. Eye Vis (Lond). 2018;5:27. Published 2018 Oct 11. doi:10.1186/s40662-018-0119-9
- Ehlers JP, Uchida A, Hu M, et al. Higher-order assessment of OCT in diabetic macular edema from the VISTA study: Ellipsoid Zone Dynamics and the Retinal Fluid Index. Ophthalmol Retina. 2019;3(12):1056-1066. doi:10.1016/j.oret.2019.06.010
- Grewal DS, O’Sullivan ML, Kron M, Jaffe GJ. Association of disorganization of retinal inner layers with visual acuity in eyes with uveitic cystoid macular edema. Am J Ophthalmol. 2017;177:116-125. doi:10.1016/j.ajo.2017.02.017
- Hayashi H, Yamashiro K, Tsujikawa A, Ota M, Otani A, Yoshimura N. Association between foveal photoreceptor integrity and visual outcome in neovascular age-related macular degeneration. Am J Ophthalmol. 2009;148(1):83-9.e1. doi:10.1016/j.ajo.2009.01.017
- Oishi A, Shimozono M, Mandai M, Hata M, Nishida A, Kurimoto Y. Recovery of photoreceptor outer segments after anti-VEGF therapy for age-related macular degeneration. Graefes Arch Clin Exp Ophthalmol. 2013;251(2):435-440. doi:10.1007/s00417-012-2034-4
- Shin HJ, Chung H, Kim HC. Correlation of foveal microstructural changes with vision after anti-vascular endothelial growth factor therapy in age-related macular degeneration. Retina. 2013;33(5):964-970. doi:10.1097/IAE.0b013e3182835f70.
- Woronkowicz M, Lightman S, Tomkins-Netzer O. The prognostic value of total macular external limiting membrane and ellipsoid zone damage for clinical outcome in treatment-resistant neovascular age-related macular degeneration. Graefes Arch Clin Exp Ophthalmol. 2020;258(11):2373-2378. doi:10.1007/s00417-020-04869-4
- Kim KM, Kim JH, Chang YS, Kim JW, Kim CG. Long-term outcomes in patients with neovascular age-related macular degeneration who maintain dry macula after three monthly ranibizumab injections. Semin Ophthalmol. 2018;33(3):371-376. doi:10.1080/08820538.2016.1247179
- Ferrara D, Silver RE, Louzada RN, Novais EA, Collins GK, Seddon JM. Optical coherence tomography features preceding the onset of advanced age-related macular degeneration. Invest Ophthalmol Vis Sci. 2017;58(9):3519-3529. doi:10.1167/iovs.17-21696
- Giocanti-Auregan A, Tadayoni R, Fajnkuchen F, Dourmad P, Magazzeni S, Cohen SY. Predictive value of outer retina en face OCT imaging for geographic atrophy progression. Invest Ophthalmol Vis Sci. 2015;56(13):8325-8330. doi:10.1167/iovs.14-15480
- Sun JK, Lin MM, Lammer J, et al. Disorganization of the retinal inner layers as a predictor of visual acuity in eyes with center-involved diabetic macular edema. JAMA Ophthalmol. 2014;132(11):1309-1316. doi:10.1001/jamaophthalmol.2014.2350
- Radwan SH, Soliman AZ, Tokarev J, Zhang L, van Kuijk FJ, Koozekanani DD. Association of disorganization of retinal inner layers with vision after resolution of center-involved diabetic macular edema. JAMA Ophthalmol. 2015;133(7):820-825. doi:10.1001/jamaophthalmol.2015.0972
- Sun JK, Radwan SH, Soliman AZ, et al. Neural retinal disorganization as a robust marker of visual acuity in current and resolved diabetic macular edema. Diabetes. 2015;64(7):2560-2570. doi:10.2337/db14-0782
- Mimouni M, Segev O, Dori D, Geffen N, Flores V, Segal O. Disorganization of the retinal inner layers as a predictor of visual acuity in eyes with macular edema secondary to vein occlusion. Am J Ophthalmol. 2017;182:160-167. doi:10.1016/j.ajo.2017.08.005
- Berry D, Thomas AS, Fekrat S, Grewal DS. Association of disorganization of retinal inner layers with ischemic index and visual acuity in central retinal vein occlusion. Ophthalmol Retina. 2018;2(11):1125-1132. doi:10.1016/j.oret.2018.04.019
- Babiuch AS, Han M, Conti FF, Wai K, Silva FQ, Singh RP. Association of disorganization of retinal inner layers with visual acuity response to anti-vascular endothelial growth factor therapy for macular edema secondary to retinal vein occlusion. JAMA Ophthalmol. 2019;137(1):38-46. doi:10.1001/jamaophthalmol.2018.4484
- Akkaya S. Spectrum of pachychoroid diseases. Int Ophthalmol. 2018;38(5):2239-2246. doi:10.1007/s10792-017-0666-4
- Moraru AD, Costin D, Moraru RL, Costuleanu M, Brănișteanu DC. Current diagnosis and management strategies in pachychoroid spectrum of diseases (review). Exp Ther Med. 2020;20(4):3528-3535. doi:10.3892/etm.2020.9094
- Lai K, Zhou L, Zhong X, et al. Morphological difference of choroidal vasculature between polypoidal choroidal vasculopathy and neovascular amd on oct: from the perspective of pachychoroid. Ophthalmic Surg Lasers Imaging Retina. 2018;49(10):e114-e121. doi:10.3928/23258160-20181002-13
- Yuan MZ, Chen LL, Yang JY, Luo MY, Chen YX. Comparison of OCT and OCTA manifestations among untreated PCV, neovascular AMD, and CSC in Chinese population. Int J Ophthalmol. 2020;13(1):93-103. Published 2020 Jan 18. doi:10.18240/ijo.2020.01.14
- Cho M, Athanikar A, Paccione J, Wald KJ. Optical coherence tomography features of acute central serous chorioretinopathy versus neovascular age-related macular degeneration. Br J Ophthalmol. 2010;94(5):597-599. doi:10.1136/bjo.2008.149724
- Ahn SJ, Kim TW, Huh JW, Yu HG, Chung H. Comparison of features on SD-OCT between acute central serous chorioretinopathy and exudative age-related macular degeneration. Ophthalmic Surg Lasers Imaging. 2012;43(5):374-382. doi:10.3928/15428877-20120628-01








